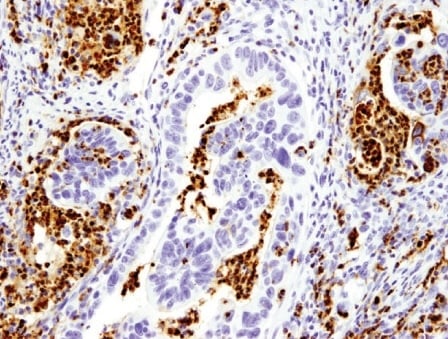

In 2022, an update was made to the Hallmarks of Cancer framework to expand beyond the eight hallmarks and two enabling characteristics originally outlined in the first two seminal papers. Among these new dimensions is the addition of a novel hallmark—Unlocking Phenotypic Plasticity, a trait of cancer cells that reflects their ability to alter their cellular identity in ways that promote tumor progression, immune evasion, and treatment resistance. While not a new concept in oncology research, the addition recognizes that phenotypic plasticity is so widespread among cancer subtypes that it merits inclusion as a distinct cancer hallmark.
This blog explores the biological basis of phenotypic plasticity, mechanisms and examples of how it arises, and its implications in therapeutic development.
< Jump to the product list at the end of this blog >
What is phenotypic plasticity?
|
Phenotypic plasticity describes the ability of cancer cells to reinvent themselves by transitioning between different cellular states. When exhibiting phenoplasticity, neoplastic cells lose—or fail to exhibit—features typically associated with terminally differentiated, non-cancerous cells. Instead, they take on traits more commonly associated with progenitor or stem-like cells, which are naturally less differentiated. This includes the capacity for sustained proliferation, the loss of which is considered a landmark feature of terminally differentiated cells, as well as the ability to adopt new phenotypic attributes. |
|
What are the Hallmarks of Cancer?The Hallmarks of Cancer1-3 are a landmark conceptual framework that organizes the key traits cancer cells acquire in order to grow, survive, and spread. Initially described by Douglas Hanahan and Robert Weinberg in 2000, the framework distills the underlying mechanisms of cancer into a series of smaller subsets to advance discovery. Initially comprising six core hallmarks, the concept was expanded in 2011 to include two additional hallmarks and two enabling characteristics, and again in 2022 with one new hallmark and four new enabling characteristics.
|
Importantly, cellular plasticity often occurs independently of genetic mutation, instead relying on nonmutational epigenetic (or epigenomic) reprogramming, another hallmark of cancer.
Essentially, by reversing the normal, deterministic processes of cellular differentiation, cancer cells can access and acquire the traits necessary for enhanced survival and proliferation in challenging environments—adaptations such as metabolic reprogramming and epithelial-mesenchymal transition. This allows tumor cells to also express a variety of characteristics crucial for their survival, invasiveness, and resistance to therapy—many of which overlap with the other Hallmarks of Cancer traits.
Which pathways are involved in phenotypic plasticity?
Central to the Hallmarks of Cancer: New Dimensions framework is the understanding that oncogenic transformation is commonly associated with the cessation, reactivation, and/or reversal of the normal, deterministic processes of cellular differentiation. One or more developmental signaling pathways are typically implicated in this transformation, including those that regulate the spatial and temporal expression of homeotic and other transcription factors that govern cell fate determination.
The main developmental pathways contributing to phenotypic plasticity include:
Wnt/β-Catenin SignalingWnt/β-Catenin regulates stem cell pluripotency and cell fate decisions during development. |
|
Notch SignalingNotch signaling is an evolutionarily conserved pathway that governs cell-fate determination during development and helps maintain adult tissue homeostasis. |
|
Hedgehog SignalingThe Hedgehog (Hh) pathway is essential for normal embryonic development and plays critical roles in adult tissue maintenance, renewal, and regeneration. |
|
TGF-β/Smad SignalingMembers of the transforming growth factor-β (TGF-β) superfamily regulate cell growth, differentiation, and development in a wide range of biological systems. |
During normal development, these signaling pathways become increasingly restricted (e.g., limited to stem cell niches) or are silenced altogether as cells reach terminal differentiation. In cancer, however, through mechanisms not fully understood—and undoubtedly dependent upon context—select developmental signaling pathways may be disrupted or aberrantly activated, leading to alterations in the fate-determining factors normally present in differentiated cells. This increased plasticity can lead to the rapid emergence of new characteristics that confer a selective advantage to the cancer cells, thereby promoting their expansion. For example, cancer cells may evolve resistance to immunological attack through the process of immunoediting, allowing them to evade detection and destruction by the immune system.4,5
This core concept adds an additional layer of adaptability and underlies the mechanisms of cancer cell evolution and the role of cancer stem cells in this process.
Mechanisms of Cellular Plasticity
Three distinct cellular mechanisms can lead to the acquisition of progenitor cell-like plasticity in tumor cells: dedifferentiation, blocked differentiation, and transdifferentiation.
Dedifferentiation
Dedifferentiation is a process during which mature, differentiated, non-proliferative cells revert to a more progenitor-like cell state and regain the ability to adopt and express new phenotypic characteristics. These traits could include other hallmarks of cancer, such as replicative immortality, which, if uncontrolled, is deleterious in fully developed tissues. The process involves developmental signaling pathways and epigenetic changes (e.g., chromatin modifications) that result in the dysregulation of genes that govern cell state.
Relevant diagrams:
A well-studied example of dedifferentiation that can facilitate cancer progression is epithelial-mesenchymal transition (EMT). During EMT, epithelial cells lose their distinctive apical-basal polarity and exhibit a motile phenotype that is more characteristic of mesenchymal cells. Because mesenchymal cells are considered to have a less differentiated phenotype than epithelial cells, the process of EMT in the context of cancer has itself been proposed as a “hallmark” example of cancer cell dedifferentiation.
Blog: Key Epithelial-Mesenchymal Transition (EMT) Markers in Cancer
A number of established cellular markers are used to identify the process of EMT. These include increased expression of established mesenchymal markers, such as vimentin, α-smooth muscle actin (α-SMA), and fibronectin. In addition, a decrease in E-Cadherin expression, along with a concomitant increase in N-Cadherin expression, may be detected—a phenomenon known as the cadherin switch.
![]() |
![]() |
| Immunohistochemical (IHC) analysis of paraffin-embedded human non-Hodgkin lymphoma using Vimentin (D21H3) Rabbit mAb (Alexa Fluor® 488 Conjugate) #9854 (green) and DAPI #4083 (blue). Increased expression of vimentin, a mesenchymal marker, can be used to identify epithelial-mesenchymal transition (EMT), which occurs during cancer cell dedifferentiation. | IHC analysis of paraffin-embedded human non-Hodgkin Lymphoma using N-Cadherin (D4R1H) Rabbit mAb #13116. An increase in N-Cadherin expression, along with a concomitant decrease in E-Cadherin expression (the cadherin switch), is commonly used to identify EMT, a natural biological process involving dedifferentiation that can facilitate cancer progression. |
A variety of inter- and intra-cellular signaling pathways have been implicated in the activation of EMT. Most notably, activation of the TGF-β signaling pathway converges on a network of key transcription factors (e.g., Twist, Snail, Slug, ZEB1) that function to regulate the expression of genes controlling the expression of epithelial and mesenchymal features.
IHC analysis of paraffin-embedded human endometrioid adenocarcinoma using ZEB1 (E2G6Y) Rabbit Monoclonal Antibody #70512.
Blocked Differentiation
Blocked differentiation occurs when incompletely differentiated progenitor cells, otherwise destined for terminal differentiation, are prevented from fully differentiating into a mature, post-proliferative state. These cells retain the phenotypic plasticity characteristics of less differentiated progenitor cells, and often continue to express lineage markers associated with an early phase of their development. They also demonstrate a proliferative capacity more reflective of stem or progenitor cells.
The classic example of blocked differentiation in cancer is Acute Myeloid Leukemia (AML), where hematopoietic progenitor cells fail to terminally differentiate and continue to proliferate. Acute promyelocytic leukemia (APL), a distinct subtype of AML, is driven by a chromosomal translocation that disrupts the retinoic acid (RA) signaling required for myeloid differentiation. A highly successful therapeutic strategy called Differentiation Therapy has been devised that restores RA signaling, thereby inducing the terminal differentiation of leukemic cells, leading to cancer remission. Myeloid lineage markers such as CD33, and MPO are commonly used to identify myeloid progenitor cells, and thus can be useful biomarkers to investigate blocked differentiation in the context of AML.
IHC analysis of paraffin-embedded colon adenocarcinoma using Myeloperoxidase (E1E7I) Rabbit Monoclonal Antibody #14569. Myeloperoxidase (MPO) is a marker of myeloid progenitor cells that can be used for investigating blocked differentiation in the context of acute myeloid leukemia (AML).
Another example is neuroblastoma, a cancer subtype originating from blocked differentiation that leads to deleterious proliferation of neural crest progenitor cells. Aberrant expression of N-Myc, a transcription factor that serves as a master regulator of neural crest cell proliferation and self-renewal, is associated with the development of neuroblastoma. The transcription factor PHOX2B is similarly implicated.
IHC analysis of paraffin-embedded human neuroblastoma using N-Myc (D4B2Y) Rabbit Monoclonal Antibody #51705.
Transdifferentiation
Transdifferentiation refers to the process by which differentiated cells phenotypically transform into another differentiated cell type, acquiring new lineage traits not previously associated with their developmental trajectory—often without an intermediate dedifferentiated, progenitor-like state occurring as part of the phenotype change.
Barrett's esophagus is a classic example, where chronic reflux-associated inflammation is observed to induce the transdifferentiation of stratified squamous epithelial cells into columnar epithelial cells that more closely resemble intestinal epithelial cells. Evidence for this transdifferentiation can come from the (aberrant) detection of markers associated with intestinal cell differentiation, such as CDX2 and MUC2, or changes in the expression patterns of specific keratin proteins, including CK7 (cytokeratin-7) and CK20 (cytokeratin-20). Notably, this transdifferentiation can be a precondition for subsequent oncogenic transformation into adenocarcinomas, a cancer subtype not typically associated with squamous epithelial cells.
IHC analysis of paraffin-embedded human colon carcinoma using CDX2 (D11D10) Rabbit Monoclonal Antibody #12306. CDX2, an intestinal cell marker, can be aberrantly expressed by transdifferentiated columnar epithelial cells during Barrett's esophagus, a condition that can increase the risk of developing esophageal cancer.
General Pluripotency Markers
Researchers can use common markers of pluripotency to characterize the types of phenotypic plasticity that occur in cancer cells.
Phenotypic markers of a pluripotent or progenitor-like cell state include those commonly used to identify embryonic stem cells (ESCs) or induced pluripotent stem cells (iPSCs), such as Oct4, Nanog, and Sox2. Alternatively, cells that have undergone dedifferentiation may express cell surface markers commonly associated with cancer “stemness”, such as CD44, CD133, or CD24. These markers serve as practical tools to distinguish tumor subpopulations with enhanced plasticity and self-renewal capabilities.
It is important to note, however, that most cancer cells are unlikely to revert to a fully pluripotent “ground state” similar to that of ESCs or iPSCs. The level of epigenetic reprogramming required to achieve such a reversal is substantial, and is unlikely to be encountered in a somatic environment. Teratomas, a type of germ cell tumor that contains all three germ cell layers (ectoderm, mesoderm, endoderm), are an extreme example of phenotypically plastic cancer cells. For this reason, these are generally understood to arise from germ-line progenitor cells, rather than the dedifferentiation of terminally differentiated somatic cells, and thus are rarely observed outside of gonadal tissues.
IHC analysis of paraffin-embedded mouse liver using CD44 (E7K2Y) Rabbit Monoclonal Antibody #37259. CD44 is commonly used as a cancer stem cell marker.
New Dimensions in Phenotypic Plasticity
Unlocking phenotypic plasticity highlights a critical shift in how we understand tumor biology: cancer cells are not fixed in their identity but instead retain or reacquire developmental programs that enhance survival, adaptability, and therapy resistance. By leveraging pathways that regulate cell fate and reactivating stem-like transcriptional networks, tumors evolve in ways that complicate treatment and drive disease progression. As one of the newest additions to the Hallmarks of Cancer framework, phenotypic plasticity underscores the importance of investigating developmental and epigenetic mechanisms in oncology research, both as fundamental biology and as a way to identify novel targets for the development of improved therapeutic approaches.
Additional Resources
Read the additional blogs in the Hallmarks of Cancer Series:
- Evading Growth Suppressors
- Nonmutational Epigenetic Reprogramming
- Avoiding Immune Destruction
- Tumor-Promoting Inflammation
- Activating Invasion & Metastasis
- Inducing or Accessing Vasculature (Angiogenesis)
- Senescent Cells
- Genome Instability & Mutation
- Resisting Cell Death
- Deregulating Cellular Metabolism
- Sustaining Proliferative Signaling
References
- Hanahan D. Hallmarks of Cancer: New Dimensions. Cancer Discov. 2022;12(1):31-46. doi:10.1158/2159-8290.CD-21-1059
- Hanahan D, Weinberg RA. The hallmarks of cancer. Cell. 2000;100(1):57-70. doi:10.1016/s0092-8674(00)81683-9
- Hanahan D, Weinberg RA. Hallmarks of cancer: the next generation. Cell. 2011;144(5):646-674. doi:10.1016/j.cell.2011.02.013
- Colson C, Whiting FJ, Baker AM, Graham TA. Mathematical modelling of cancer cell evolution and plasticity. Curr Opin Cell Biol. 2025;95:102558. doi:10.1016/j.ceb.2025.102558
- Venkatesan S, Swanton C, Taylor BS, Costello JF. Treatment-Induced Mutagenesis and Selective Pressures Sculpt Cancer Evolution. Cold Spring Harb Perspect Med. 2017;7(8):a026617. Published 2017 Aug 1. doi:10.1101/cshperspect.a026617



